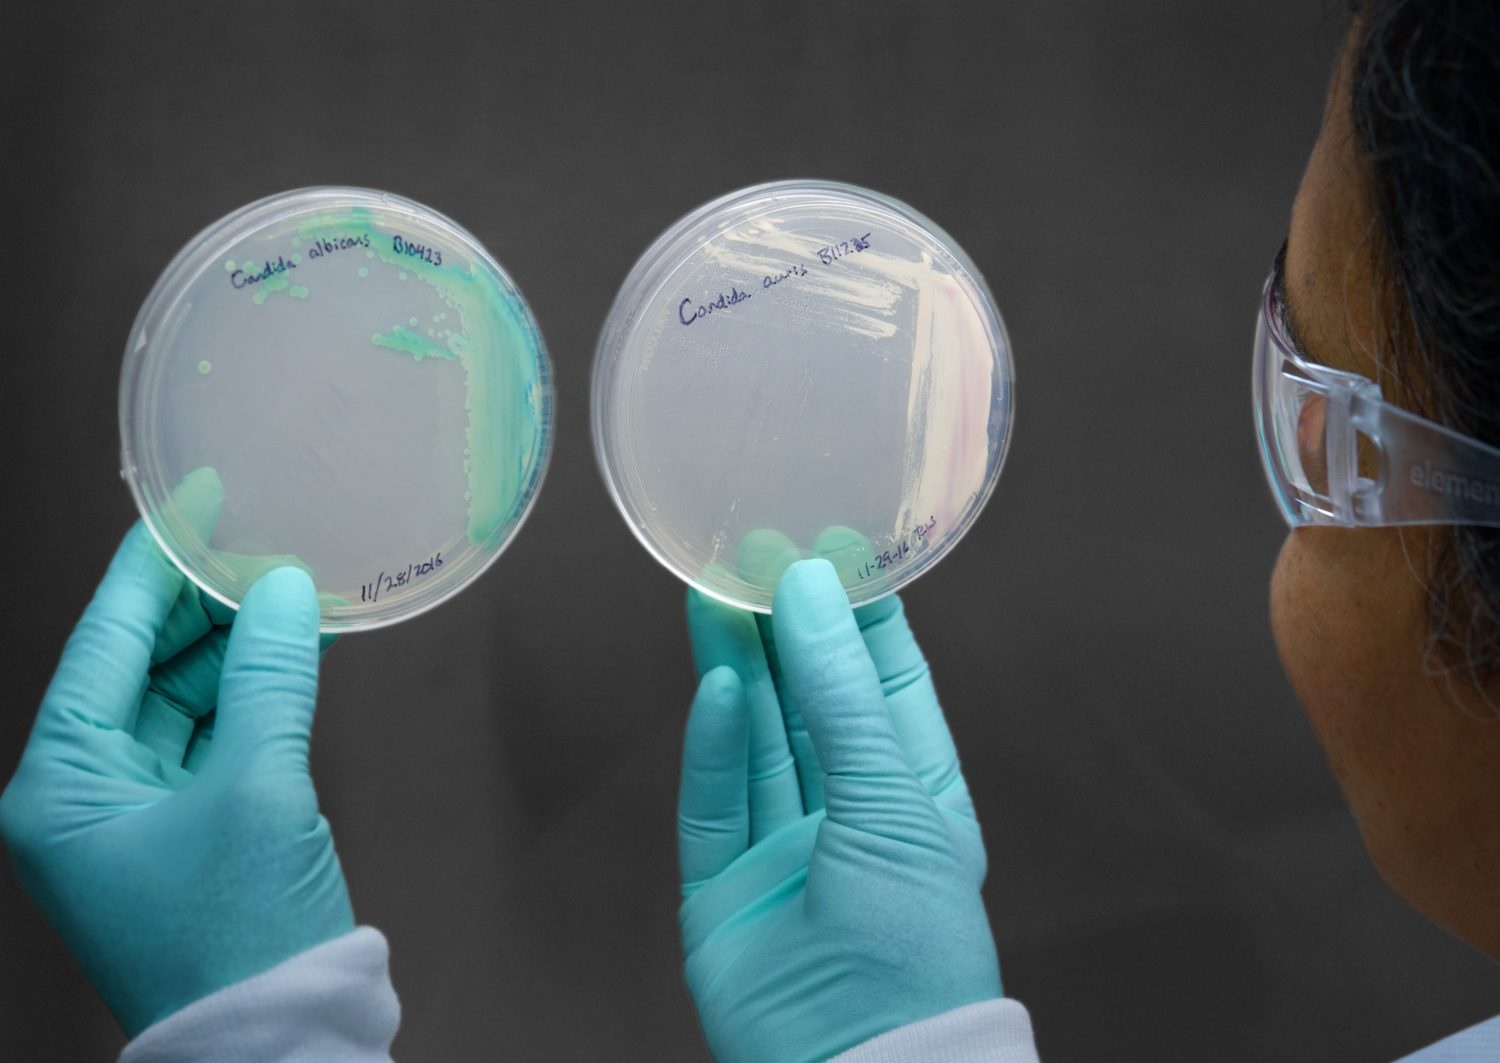
nam anh 2

|
|
Nấm C. auris đang gây lo ngại tại Mỹ vì số lượng người nhiễm nấm ngày càng tăng. Ảnh: Thinkstock. |
Theo NBC News, nghiên cứu mới của chính phủ Mỹ cho thấy một loại nấm kháng thuốc và có khả năng gây chết người đang lây lan nhanh chóng ở các cơ sở chăm sóc sức khỏe của nước này.
Loại nấm men tên là Candida auris, hay C. auris, có thể gây bệnh nặng cho những người có hệ miễn dịch yếu.
Tình trạng nhiễm nấm tại Mỹ
Vào 20/3, các nhà nghiên cứu từ Trung tâm Kiểm soát Dịch bệnh (CDC) cho biết số người được chẩn đoán bị nhiễm trùng cũng như số người được phát hiện có C. auris trên cơ thể đã tăng lên ở mức báo động kể từ khi căn bệnh xuất hiện lần đầu tiên ở Mỹ.
Tiến sĩ Meghan Lyman, tác giả chính của nghiên cứu, Giám đốc y tế tại Chi nhánh điều trị Bệnh nấm của CDC, cho biết: “Sự gia tăng đáng kể trong những năm gần đây thực sự khiến chúng tôi lo ngại. Chúng tôi nhận thấy căn bệnh không chỉ xuất hiện ở những khu vực đang có sự lây lan mà còn ở những khu vực mới”.
 |
| Loại nấm này không ảnh hưởng đến người khỏe mạnh nhưng có thể gây tử vong với bệnh nhân có miễn dịch kém. Ảnh: Infectious Disease ADVISOR. |
CDC đưa ra cảnh báo mới trên Annals of Internal Medicine trong hoàn cảnh Mississippi đang phải chiến đấu với sự bùng phát của loại nấm này.
Tammy Yates, người phát ngôn của cơ quan quản lý y tế Bang Mississippi, viết trong một email rằng kể từ tháng 11/2022, ít nhất 12 người đã bị nhiễm C. auris với 4 trường hợp tử vong có khả năng liên quan đến loại nấm này.
Hai cơ sở chăm sóc sức khỏe dài hạn liên tiếp ghi nhận ca lây nhiễm. Một số cơ sở khác trong tiểu bang cũng có các trường hợp tương tự.
Người phát ngôn Tammy Yates nói: "Thật không may, các sinh vật kháng nhiều loại thuốc như C. auris đang trở nên phổ biến hơn. Một số đối tượng như cư dân trong các cơ sở chăm sóc dài hạn là người dễ mắc bệnh nhất".
Theo CDC, loại nấm này có trên da và khắp cơ thể. Nó không phải là mối đe dọa đối với người khỏe mạnh, nhưng đối với người mắc bệnh, khoảng 1/3 bệnh nhân đã tử vong.
Số liệu báo động của bệnh nhân mắc nấm C. auris
Trong báo cáo của CDC, các nhà nghiên cứu phân tích dữ liệu của cơ quan quản lý y tế tiểu bang và địa phương về người bị bệnh nấm từ năm 2016 đến 31/12/2021, cũng như những người có nấm cư trú (không bị bệnh nhưng đang mang mầm bệnh trên người).
Trong hai năm 2019-2020, số ca nhiễm tăng 59%, lên tới 756 người. Vào 2021, các ca mắc lên tới 1.471, tăng thêm 95%. Các nhà nghiên cứu cũng phát hiện vào năm 2020, tỷ lệ người có nấm cư trú trên cơ thể tăng 21% so với năm 2019. Tỷ lệ này tăng lên 209% vào năm 2021, với con số 4.041 bệnh nhân. Nghiên cứu mới cho thấy C. auris hiện được phát hiện ở hơn một 1/2 số bang của Mỹ.
|
| Số lượng người mắc nấm C. auris ngày càng tăng nhanh qua từng năm. Ảnh: The MS Wire. |
Điều đáng lo ngại nhất là số lượng mẫu nấm kháng lại các phương pháp điều trị thông thường ngày càng tăng. Tiến sĩ Lyman hy vọng các bài báo đề cập đến C. auris sẽ khiến những nhà cung cấp dịch vụ chăm sóc sức khỏe chú ý tới căn bệnh này và thúc đẩy các cơ sở kiểm soát lây nhiễm tốt.
Phương pháp ngăn chặn
Tiến sĩ Waleed Javaid, nhà dịch tễ học, chuyên gia về bệnh truyền nhiễm, Giám đốc Phòng ngừa và Kiểm soát nhiễm trùng tại Mount Sinai Downtown ở New York, cho biết: “Đây là bệnh nhiễm trùng xảy ra ở những người ốm nặng và mắc nhiều bệnh khác”.
Ông Javaid cho hay ngay cả khi C. auris lây lan ra cộng đồng, nó cũng không phải là mối lo ngại đối với người khỏe mạnh, miễn là họ không thực hiện các phương pháp xâm lấn như đưa ống thông vào mạch máu.
Ông nói thêm ngăn chặn nấm lây lan trong các đơn vị chăm sóc đặc biệt của bệnh viện mới là vấn đề chính. Thật không may, C. auris không chỉ cư trú ở người mà còn có thể ở trong phòng bệnh nhân.
Vị chuyên gia nhận định: “Nấm C. auris có khả năng sống sót trên các bề mặt rất cao. Nó có thể bám vào tường, dây cáp, giường, ghế. Chúng tôi phải làm sạch mọi thứ bằng thuốc tẩy và đèn UV”.
 |
| Các cơ sở y tế phải vệ sinh bằng thuốc tẩy và đèn UV để ngăn ngừa sự lây lan của C. auris. Ảnh: octoclean. |
Tiến sĩ Graham Snyder, Giám đốc y tế phòng chống nhiễm trùng tại Trung tâm Y tế Đại học Pittsburgh, cho biết mặc dù loại nấm này được ghi nhận lần đầu tiên vào năm 2009 ở châu Á, các nhà khoa học xác định C. auris lần đầu xuất hiện trên khắp thế giới khoảng một thập kỷ trước đó.
Trong quá khứ, C. auris bị đánh giá nhầm là một loại nấm khác. “Các loại mầm bệnh kiểu này vốn rất hiếm. Sau đó, chúng xuất hiện ngày càng nhiều ở những nơi khác và trở nên phổ biến”, ông Snyder nói.
Tiến sĩ Snyder cho biết điều quan trọng là phải ngăn chặn mầm bệnh để nó không lan rộng ra ngoài bệnh viện và các cơ sở chăm sóc y tế dài hạn.
Muốn ăn uống lành mạnh nhưng hay stress công việc? Muốn tập thể dục đều đặn nhưng hay làm việc trễ? Mục Sức khỏe của Zing giới thiệu một số sách để đồng hành cùng bạn từ phòng gym đến đường chạy, từ văn phòng đến bếp ăn. Tuyển tập này sẽ cung cấp thêm nhiều lựa chọn, và bớt đi một số nỗi lo trên hành trình cân bằng cuộc sống hiện đại.


